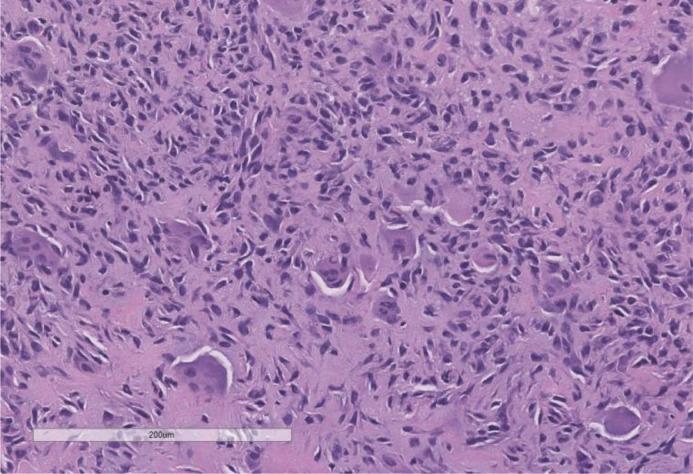

一例罕见的累及无名指远节指骨的软骨母细胞瘤。
A rare case of chondroblastoma involving the distal phalanx of the ring finger.
作者信息
Radzinsky Ethan, Bateni Cyrus, Theriault Raminta, Thorpe Steven W, Bindra Jasjeet
机构信息
Department of Radiology, University of California Davis School of Medicine, 4860 Y St. Suite 3100 Sacramento, CA 95817, USA.
Department of Orthopedic Surgery, University of California Davis School of Medicine, CA, USA.
出版信息
Radiol Case Rep. 2023 May 11;18(7):2441-2446. doi: 10.1016/j.radcr.2023.04.024. eCollection 2023 Jul.
Chondroblastoma, a rare benign bone tumor, is typically found in the epiphysis of long bones, with hand involvement being particularly uncommon. We present a case of an 11-year-old female with chondroblastoma involving the fourth distal phalanx of the hand. Imaging revealed a lytic, expansile lesion with sclerotic margins and no soft tissue component. A preoperative differential diagnosis included intraosseous glomus tumor, epidermal inclusion cyst, enchondroma, and chronic infection. The patient underwent open surgical biopsy and curettage for both diagnostic and treatment purpose. The final histopathologic diagnosis was chondroblastoma.
软骨母细胞瘤是一种罕见的良性骨肿瘤,通常发生于长骨的骨骺,累及手部的情况尤为少见。我们报告一例11岁女性,其手部第四指远节指骨发生软骨母细胞瘤。影像学检查显示为一溶骨性、膨胀性病变,边缘硬化,无软组织成分。术前鉴别诊断包括骨内血管球瘤、表皮样囊肿、内生软骨瘤和慢性感染。为明确诊断及进行治疗,患者接受了开放性手术活检及刮除术。最终组织病理学诊断为软骨母细胞瘤。